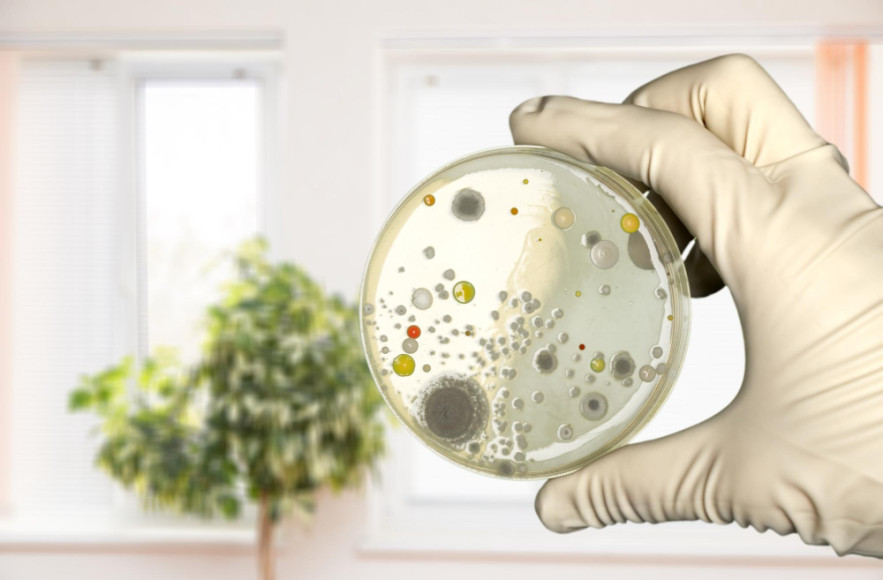

Élelmiszerbiztonsággal foglalkozó szakemberek szerint a konyharuhák, konyhai törülközők meglepően gyorsan szennyeződhetnek kórokozókkal olyan mértékben, hogy azok igen könnyen különböző betegségeket okozhatnak.
Az emberek kézmosás előtt is gyakran megtörlik a kezüket, vagy éppen úgy érnek a törülközőkhöz, hogy nem megfelelő módon mosták kezet. Ráadásul a szennyezett konyharuhába újra és újra beletöröljük a kezünket, ezzel pedig újra és újra 'utaztatjuk' a kórokozókat a kezünk és a törlő között.
Bár az ételmérgezések mindössze kilenc százaléka kötődik az otthonunkhoz, a szakemberek szerint az élelmiszerrel kapcsolatos megbetegedések jóval gyakoribbak. A kutatások szerint a "körbefertőződés" egyik forrása a takarításra és kéztörlésre használt konyharuha.
Hol vannak a lakás legszennyezettebb pontjai?
Jeannie Sneed, a Kansas State University élelmiszer-biztonsággal foglalkozó kutatója a csapatával több vizsgálatot is végzett a konyhai viselkedéssel, elsősorban a takarítási szokásokkal kapcsolatban.
"A vizsgálatban részt vevők nagyon gyakran használtak konyhai törlőket, papír és textil anyagúakat is, azonban nem minden esetben szárításra alkalmazták ezeket. Megérintették ezeket kézmosás előtt és után, ráadásul újra és újra használták ezeket. Ezzel pedig egyszerűen visszaszennyezték a kezüket" - mondta Sneed A kutatásból kiderült, hogy a szalmonella még akkor is képes elszaporodni a konyharuhán, törlőkendőn, ha kiöblítették.
Egy másik lehetséges fertőzésforrás a mobiltelefon és a tablet lehet: a videófelvételek elemzése során kiderült, hogy nagyon sokan használják ezeket az eszközöket főzés közben, anélkül, hogy utána megfelelő módon fertőtlenítenék ezeket.
Az okostelefonokat ráadásul nemcsak a konyhában használjuk, sokan a vécére vagy a fürdőszobába is magukkal viszik ezeket. Így pedig nagyon sok kórokozót utaztathatunk, emiatt sokszorosára növekedhet a fertőzések veszélye.









